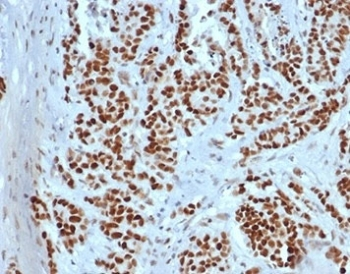
Recombinant MSH2 Antibody

You have no items in your shopping cart.
- Recombinant MSH2 Antibody [orb2636732]
IHC-P, WB
Canine, Feline, Human
Mouse
Recombinant
Unconjugated
100 μg - Recombinant MSH2 Antibody [orb1151551]
IHC-P, WB
Canine, Feline, Human
Mouse
Recombinant
Unconjugated
100 μg, 20 μg - Recombinant Histone H1 Antibody [orb639702]
FACS, IF, IHC-P, WB
Human, Mouse, Rat
Rabbit
Recombinant
Unconjugated
100 μg, 20 μg - Recombinant FSP1 Antibody / S100A4 [orb639913]
FACS, IF, IHC-P, WB
Human, Mouse
Mouse
Recombinant
Unconjugated
100 μg, 20 μg - GPC3/Glypican-3 Antibody (MMAE) [orb1805490]
ELISA, FA, FACS, In vivo
Human
Recombinant
MMAE
100 μg, 1 mg - Rab 2B rabbit pAb Antibody [orb770663]Featured

ELISA, IHC, WB
Human, Mouse, Rat
Recombinant
Unconjugated
50 μl, 100 μl